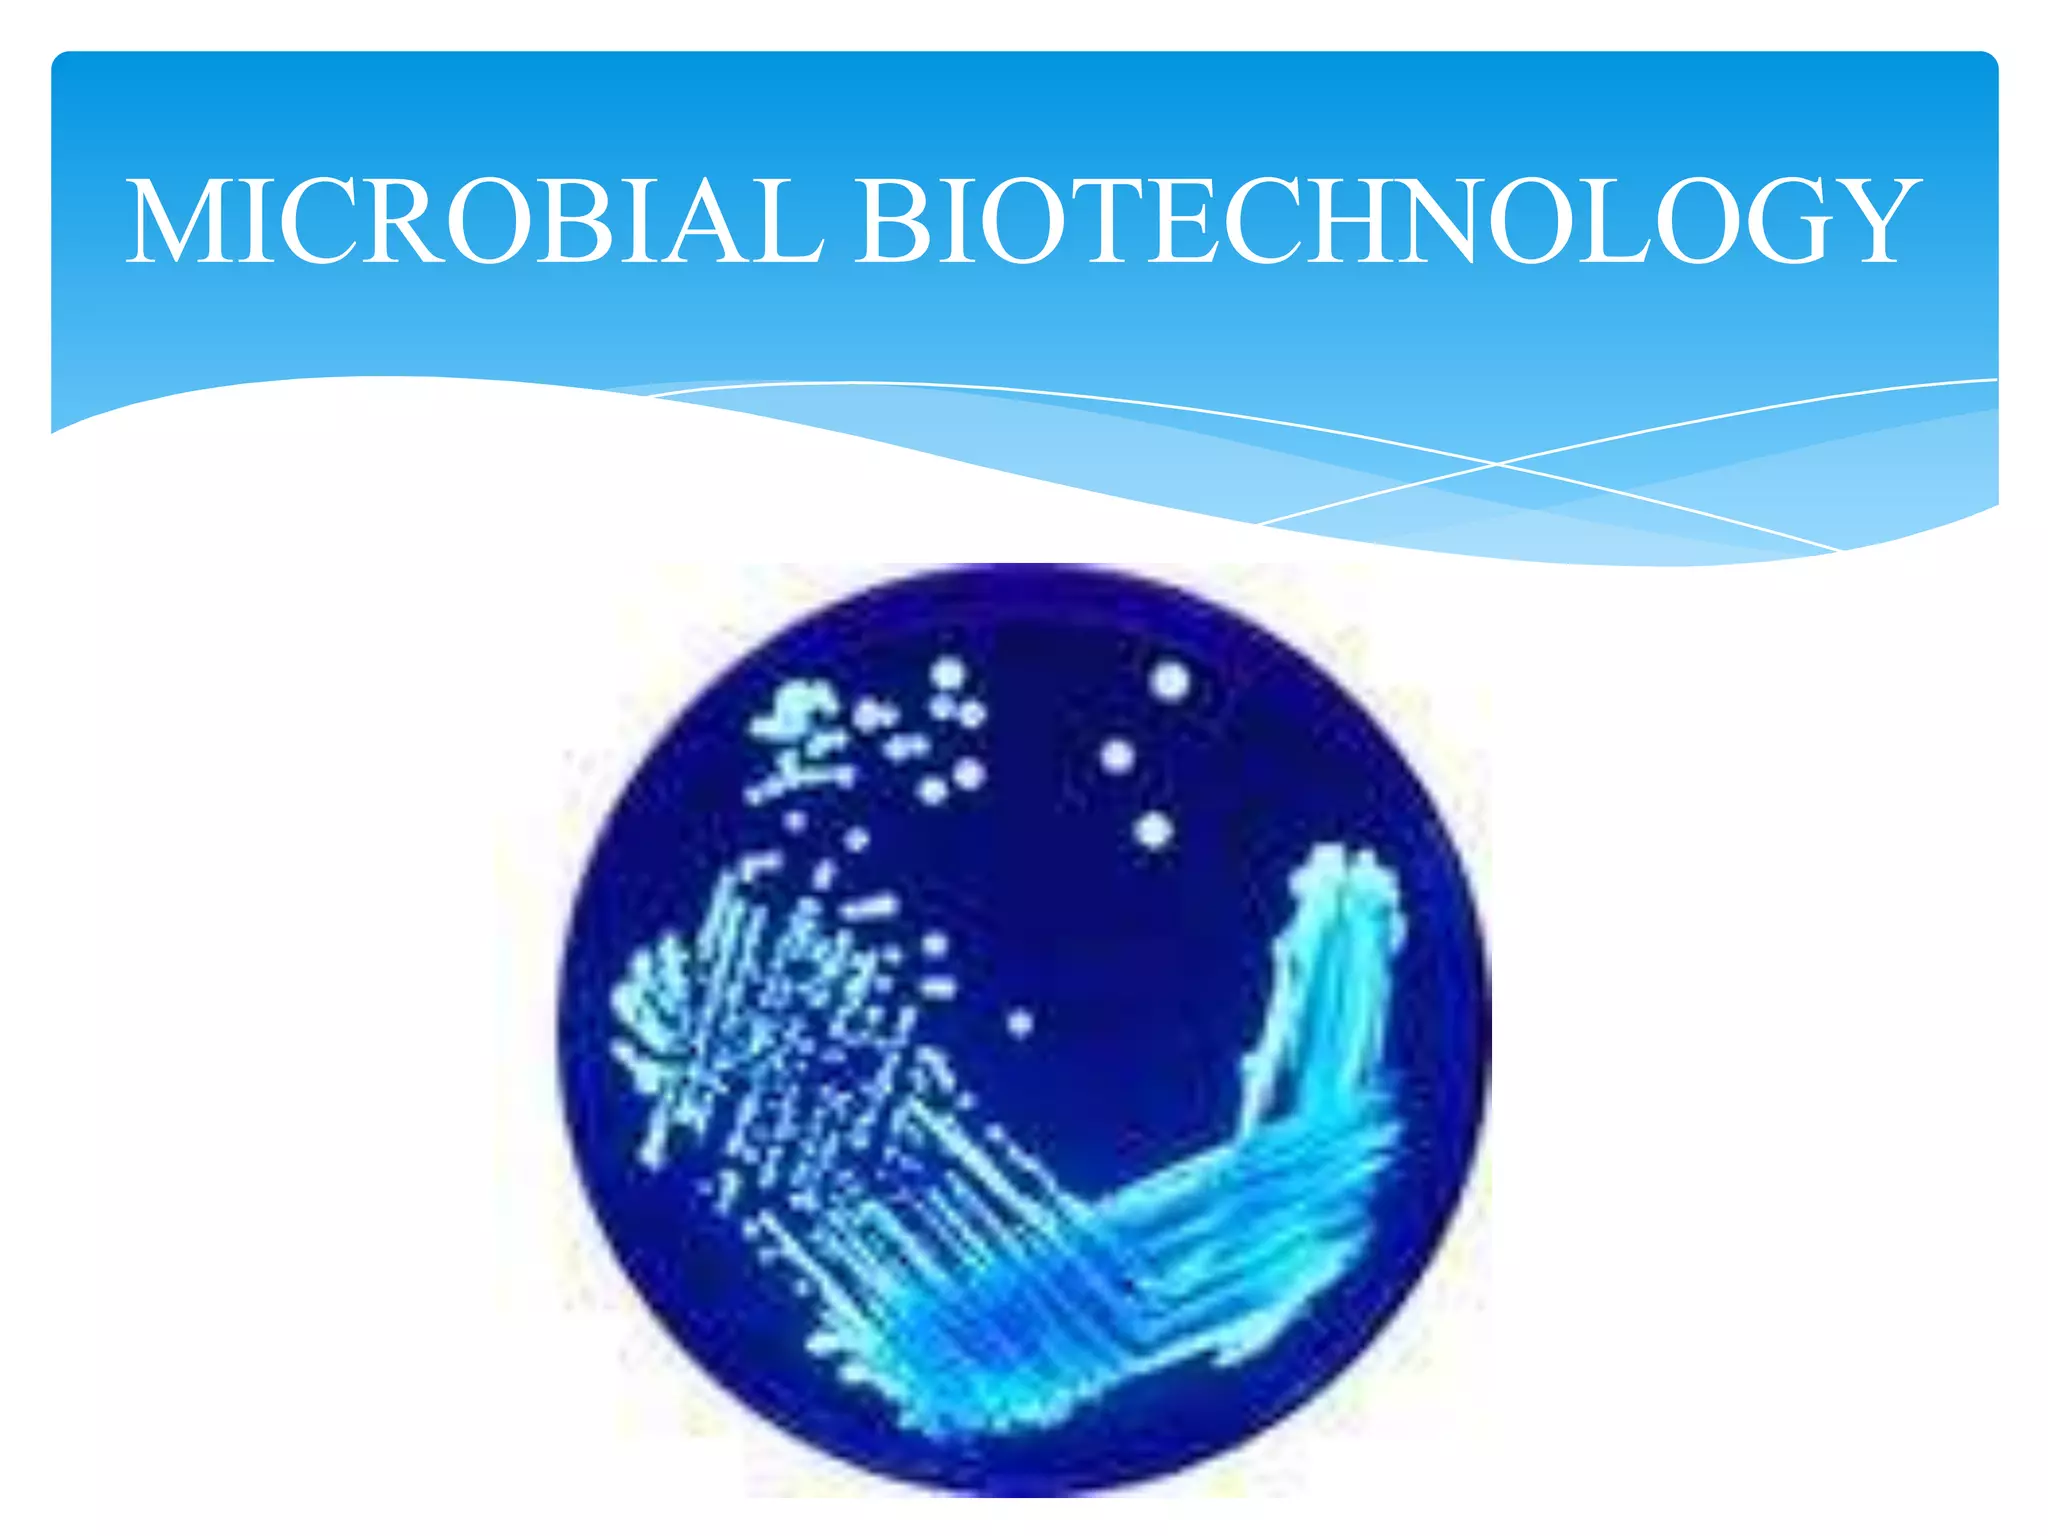

Microbial biotechnology utilizes microorganisms and their genetic material to produce a wide range of products. It covers areas like recombinant protein production, microbial insecticides, mineral extraction, and bioremediation. Microbes are well-suited for industrial production due to their ability to be genetically manipulated to greatly increase metabolite yields. Traditional applications include using mutants and process optimization to overproduce primary metabolites like amino acids, organic acids, alcohols, and vitamins through fermentation.